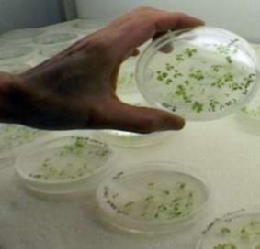
Report

GIB4I/SMEs intervista Giancarlo Elia VALORI autore di «Geopolitica del cibo – Una sfida per grandi potenze»
1. In premessa voglio ricordare che la mia recente iniziativa editoriale, «Geopolitica del cibo – Una sfida per grandi potenze», realizzata in prosecuzione della precedente opera, «Geopolitica dell’acqua – La corso all’oro del nuovo millennio», entrambe pubblicate da Rizzoli, ha lo scopo di far conoscere la rilevante importanza dell’alimentazione, quale elemento essenziale per la sopravvivenza dell’uomo, di cui tutti devono essere in grado di poter reperire sia l’acqua che il cibo.
É un diritto dell’uomo, infatti, avere accesso ad un “cibo nutriente e sicuro, adeguato per soddisfare i bisogni nutrizionali di base”, come lo è anche “il diritto di disporre di acqua pulita e di qualità accettabile, in quantità idonea e a costi sostenibili”.
Nonostante ciò, la fame, la malnutrizione e la denutrizione continuano ad essere un problema mondiale. La fame descrive una condizione in cui un individuo non ha accesso ad una quantità sufficiente di cibo; mentre la malnutrizione può essere causata anche dalla fame, dalla scarsa qualità degli alimenti e da malattie.
Solo realizzando seriamente l’importanza del diritto ad una alimentazione adeguata, di cui gli stessi governi dovranno essere responsabili, si potranno debellare fame, malnutrizione e denutrizione.
2. Sulla scia di tali presupposti, a seguito di spunti e meditazioni con l’amico Shimon Peres, Presidente dello Stato di Israele, ho voluto realizzare le due opere, per ultima quella sul cibo, allo scopo di edificare un mondo migliore, dove possano emergere non solo pace e concordia, ma anche progresso e prosperità fra i popoli.
Su queste metafore si è soffermato anche Papa Francesco in occasione della “Giornata mondiale della gioventù” a Rio de Janeiro, al fine di attirare l’attenzione del mondo sulle diseguaglianze sociali e sulla povertà.
3. Oggi, comunque, c’è un problema di accessibilità agli alimenti, come dimostra il persistere dei paradossi del sistema globale che ha declassato il cibo a merce:
fame per un miliardo di persone nei paesi poveri (a cui spesso si tenta di dare la falsa promessa degli Ogm come soluzione al problema del cibo) a fronte di obesità e dello spreco di 1/3 del cibo nei paesi ricchi; cementificazione e degrado del suolo agricolo a fronte di land grabbing (71 milioni di ettari dal 2000 ad oggi). Domani al problema dell’accessibilità al cibo si aggiungerà probabilmente anche quello della sua scarsità.
 Gli elementi attuali indicano che il mondo ha sempre più fame: un dato allarmante che è percepito debolmente in Occidente.
Gli elementi attuali indicano che il mondo ha sempre più fame: un dato allarmante che è percepito debolmente in Occidente.
Nonostante gli straordinari avanzamenti della scienza e della tecnologia, il varo di ambiziosi programmi di aiuto mondiale, gli impegni assunti nel corso dei decenni dai paesi delle aree più ricche della terra, la piaga della carestia alimentare continua a colpire quotidianamente milioni di esseri umani.
Quali le cause?
Esse sono diverse e variegate, tra le principali, indico: l’agricoltura globale, che si trova di fronte a sfide del tutto nuove; le falde idriche calano; le rese cerealicole hanno raggiunto il loro limite; le temperature globali aumentano e l’erosione dei suoli continua ad aggravarsi.
Sfamare la popolazione mondiale, che cresce ogni anno di 80 milioni di individui, diventa sempre più difficile.
E gli stati che possono permetterselo corrono all’estero ad accaparrarsi terre coltivabili con annesse risorse idriche.
Il land grabbing (cioè, l’accaparramento di terreni) rappresenta un fenomeno nuovo all’interno della geopolitica sulla scarsità alimentare, in cui il cibo ha assunto la stessa importanza del petrolio e il terreno agricolo è diventato prezioso come l’oro.
Le ricadute del cibo, in termini di prezzi mondiali, sono sotto gli occhi di tutti.
Il cibo, come l’acqua, è l’anello debole della nostra società e rischia di diventare un importante fattore di instabilità politica.
E’ facile quindi intuire come un moderno capitalismo si stia stagliando all’orizzonte attratto dalla possibilità di immensi guadagni su un bene di assoluta sopravvivenza.
4. Di conseguenza anche le nostre politiche nazionali dovrebbero concentrare maggiormente l’impegno verso il settore dell’alimentazione, ponendo un’attenzione particolare alla filiera agro-alimentare, che riveste un ruolo di primissimo piano nelle dinamiche tra uomo e ambiente, allo scopo di:
❖ leggere in anticipo gli scenari globali nel rapporto tra domanda e offerta;
❖ rovesciare la gerarchia dell’agenda corrente e collocare il cibo tra i temi di primaria importanza nazionale;
❖ velocizzare azioni organiche in difesa del suolo e dell’impresa agricola;
❖ avviare efficaci iniziative indirizzate a riconoscere il valore strategico della filiera agroalimentare, al fine di ribaltare quel processo di impoverimento che ha trasformato il nostro Paese in un “deserto di contrassegni e marchi”, in conseguenza di scellerate politiche di delocalizzazione dell’industria agroalimentare italiana.
5. In tale quadro, ritengo che una risorsa importante per il rilancio della nostra filiera agroalimentare è rappresentata dall’Expo Milano 2015, oggi al centro dell’attenzione mondiale, perché in grado di orientare i visitatori alla scoperta di risorse nascoste della natura, di cui è oltremodo ricco il nostro territorio, nonché di processi che stanno all’origine del percorso alimentare nostrano.
Ritengo comunque che il filo rosso della sostenibilità sarà anche la guida e la trama dell’analisi di tutti i segmenti della filiera agroalimentare alla scoperta di una stupefacente varietà di prodotti, di mezzi e di processi:
ciascuno di essi si mostrerà nel suo legame con i territori, con le identità da cui sorgono, con i valori che il prodotto alimentare comunica nonché con i più avanzati sistemi di trasformazione e di distribuzione.
Partendo da queste basi, l’Expo Milano 2015 si presenta come una proiezione verso il futuro, riconoscendo all’innovazione un ruolo strategico per adeguare tutti i fattori che ruotano intorno all’alimentazione e identifica in essa un oggetto specifico di investimenti sul piano del capitale umano, delle risorse economiche e del quadro normativo.
In questo senso l’innovazione è anzitutto una strategia vincente non solo per le politiche di internazionalizzazione, ma anche congiunta alle politiche per l’innovazione.
Per cui l’innovazione della nostra filiera agroalimentare può diventare il vero elemento di partnership tra Paesi e tra grandi e piccole imprese.
Sano sviluppo e capacità di innovazione si integrano e possono generare risultati sorprendenti prima ancora che per entità di risorse economiche, per capacità di cogliere e sostenere il nuovo quando si presenta.
6. L’Europa, in tale quadro, costituisce la cornice di riferimento naturale per il nostro Paese, con la giusta dimensione per avere la forza e l’autorevolezza di costruire un contesto di regole a salvaguardia dei beni comuni.
Le politiche dei singoli stati nazionali infatti – uscite profondamente indebolite dalla globalizzazione economica e finanziaria degli ultimi decenni – costituiscono una barriera arrugginita rispetto a forze di carattere transnazionale spesso di natura oligarchica.E’ necessario lavorare alacremente ad una migliore edificazione dell’Unione europea, dotandola di forti istituzioni politiche capaci di orientare la crescita e il progresso e ricondurre le spinte disgreganti in atto.
Dal punto di vista della nostra filiera agroalimentare dobbiamo essere in grado di portare pienamente “l’Italia in Europa”, facendo sì che la nuova Politica agricola comunitaria riconosca il valore strategico del “modello italiano” e le sue straordinarie peculiarità, consentendo che esso diventi patrimonio della comunità e possa contaminare virtuosamente il pensiero comunitario.
7. Ricordo che un mancato sviluppo della filiera agroalimentare, così come un ulteriore decadimento nello specifico settore, comprometterebbe duramente la nostra ripresa.
Vi sono beni dalla cui stabilità dipendono le energie stesse e la coesione dell’intera comunità.
Tra queste segnalo la filiera agroalimentare, che consente di valutare il suo sviluppo in una logica di benessere, dove, oltre al consumo di cibo, c’è la cultura dei territori, la tipicità e la creatività di tutte le imprese che lo hanno originato. Dentro al cibo c’è la sicurezza alimentare che il sistema-Italia ha garantito negli anni. C’è anche la qualità e la diversificazione assicurata dalle attività che vengono sviluppate ininterrottamente per difendere la biodiversità.
Si tratta comunque di tutta una serie di componenti immateriali che quando ci fanno stare a tavola ci fanno stare bene al di là del Prodotto interno lordo.
8. Ricordo comunque che siamo orientati e sempre più abituati a pensare ad una globalizzazione che riguarda i capitali, le grandi aziende manifatturiere, le imprese “mature”, le reti dei mass media; oppure all’universalizzazione delle scelte geopolitiche a quelle dei “valori” o delle mitologie politiche à la mode.
Ma, ormai, la mondializzazione dell’economia l’abbiamo nel piatto, nei tessuti, nei minimi oggetti della vita quotidiana. E’ un universo che condiziona, anche psicologicamente, la nostra vita biopsichica.
In Italia, ad esempio, la francese Lactalis possiede Parmalat, oltre a Galbani, Locatelli e Invernizzi.
E meno male che De Gaulle riteneva ingovernabile un paese dove si producono ben trecento tipi di formaggio; gli arabi del
Fondo Sovrano del Qatar, un Paese che ha speso il 4% del suo Pil per sostenere i “Fratelli Musulmani” del deposto Presidente egiziano Morsi, hanno acquistato i diritti di Missoni nel settore vitivinicolo, di cui il Corano espressamente proibisce qualsivoglia uso;
una nota azienda pavese del riso, ben nota agli appassionati di spot televisivi, è ormai per un quarto in mano agli spagnoli. Oppure, una birra con i baffi è ormai del tutto sudafricana. La Gancia è controllata da un oligarca russo, banchiere e produttore di una comune vodka, mentre molte note aziende italiane di salumi sono, anch’esse, in mano spagnola. Che notoriamente è una Nazione che vive di bocadillos di ottimo prosciutto della Meseta.
Insomma, anche in un Paese ricchissimo di tradizioni gastronomiche regionali e locali come il nostro, dove il buon mangiare è di prammatica, la globalizzazione del cibo è ormai un fait accompli.
Un successo per l’Italian way del cibo, forse, ma anche una debolezza strutturale delle nostre aziende, troppo piccole per globalizzarsi o troppo grandi per non poter tentare la via del grande mercato globale. Gli errori di un ingenuo gigantismo finanziario e la psicologia da parvenu hanno fatto il resto.
9. Il mercato del cibo ha comunque molti costi incomprimibili, oltre ad un certo limite di gestione, produzione, mantenimento, stoccaggio, pubblicità e distribuzione. Pur essendo un bene assolutamente primario è fortemente differenziato per ovvi motivi climatici e storici.
Nessuno fuori dalle Highlands scozzesi mangerebbe lo Haggis, insaccato di interiora di pecora con cipolla, grasso di rognone, spezie, farina e brodo. A venderlo a Palermo, dove si usa il “pane con la milza”, scoppierebbe una rivolta popolare pari a quella dei fasci siciliani.
Per non parlare del fatto che il cibo è sempre, malgrado tutte le chimiche più portentose, un prodotto a scadenza ravvicinata.
La chimica del cibo globale costa il 7-8% di ogni confezione venduta. Quindi è inevitabile che le aziende che se ne occupano siano fortemente verticalizzate e diffuse nel globo, almeno per quel che riguarda il low and medium food.
Comporre i costi di un bene naturalmente deperibile è, sul piano manageriale, un meccanismo complesso più di quanto non si creda.
I grandi gruppi di ‘food & beverage” fanno comunque i loro più alti profitti nei paesi in via di sviluppo, anche se potrebbe sembrare ragionevole il contrario, mentre operano con una strategia recessiva nei mercati del primo mondo, dove la concorrenza è più forte, le forniture locali più presenti ed i costi di pubblicizzazione/differenziazione artificiale del prodotto ben più rilevanti. Ricorrere alla chimica non avrebbe senso.
Il mercato più ricco, in prospettiva, sarà quello della Cina, dove ben 300 milioni di persone ( la popolazione della UE, più o meno) sta uscendo dalla fase di estrema povertà per arrivare a quello del sostentamento autonomo orientato a quei consumi che Galbraith chiamava “affluenti”.
Il mercato russo dovrebbe raddoppiare di volume nei prossimi cinque anni,
e queste operazioni le possono fare solo le Big Ten del cibo industriale, non certo i piccoli ma splendidi caseifici della Food Valley parmigiana.
L’India sarà il terzo mercato mondiale del cibo.
Il Brasile seguirà a ruota, con consumi in crescita del 12-15% ogni anno.
Andremo verso una semplificazione del cibo, un global taste e una omogeneizzazione delle abitudini, che prevedono un consumo compulsivo, spesso chimicamente esaltato, a piccole dosi e costante nell’arco della giornata, semi casuale e legato a quello che Freud chiamava l’istinto del piacere.
Il cibo come sostituto universale, un surrogato per tutte le piccole e grandi tragedie quotidiane.
Dolcificanti, esaltatori di sapore, coloranti, saranno la “copertura” di una base produttiva sempre più eguale a sé stessa.
La “copiatura” dei global brands di successo diverrà la norma, per un mercato di nuovi venuti che non è abituato alla varietà del cibo.
Si pensi alla Mecca-Cola dei fondamentalisti islamici. La Ferrero con la sua Nutella, più copiata della “Gioconda” di Leonardo. Ne sa qualcosa, anche per quel che riguarda l’immenso mercato cinese, dove ha gestito una causa, vincendola, contro un succedaneo, una sorta di surrogato locale.
Le vere grandi imprese tra le Big Ten del cibo operano con almeno 400 diversi marchi, come la Unilever olandese, con tassi di profitto oltre il 10%.
Oppure con almeno 550 nomi diversi per prodotti simili, come accade con una multinazionale del cibo americana, che opera anch’essa globalmente. Un unicum nel sistema delle aziende manifatturiere, per tassi di crescita e redditività unitaria dei prodotti.
Ciò porterà, come spiego nel mio libro, ad una costante crescita degli investimenti finanziari nel “food & beverage”.
Quindi il nuovo mercato mondiale del cibo è un oligopolio quasi naturale, esso si concentra sul prodotto finito e ben confezionato, più che soddisfa l’occhio sarà, lo è già oggi, la regola, con i food designers, che ricreano il panino con la polpetta, rendendolo sublime per l’immaginario sociale.
Il nuovo mercato-mondo trascura le produzioni intermedie, che non rendono mai molto bene.
Poi costringe le aziende di distribuzione, comunque grandi, ad una forte restrizione dei loro utili marginali.
Inoltre si perderà, perché la grande produzione delle Big Ten ci costringerà a farlo, il gusto del cibo che oggi si dice a “chilometri zero”, la cura delle mamme, la fantasia spesso geniale del “cibo povero”.

The Ten Major Food Companies: North Americans are currently buying 90 percent of their food from only 10 companies in the world.
La creazione ex nihilo del piatto giusto per i poveri, come è accaduto per il “lardo di Colonnata”, asse saluberrimo della nutrizione per i cavatori anarchici e mazziniani del marmo di Carrara.
Saremo, con danni per la salute ben prevedibili, pieni di cibi semplicissimi, spesso con “basi” quasi identiche, che però variano dal salato al dolce, dal piccante al morbido.
Standardizzare il gusto per omogeneizzare stili di vita, reazioni psichiche, comportamenti immediati, modelli di spesa e ritmi del rapporto tra lavoro e tempo libero. E’ tutto già scritto.
10. Sul cibo la finanza è entrata In modo pesantissimo.
Ogni mercato globalizzato dipende direttamente dai cicli finanziari, che spesso ne dettano perfino i tempi di produzione, progettazione del prodotto, marketing.
I futures sulle materie prime del cibo globale (si pensi che le grandi aziende che fanno marketing del tè sono solo tre nel mondo) generano liquidità in contrasto con il calo degli altri mercati future monetari o legati al sistema petrolifero.
Quindi, quando i prezzi calano nei petroli e nelle materie prime minerarie “non oil”,
una grande massa speculativa di capitali si rivolge alla finanza parallela e sempre OTC, Over the Counter, a trattativa privata e “coperta”, e vuole solo e unicamente la realizzazione di un profitto monetario in brevissimo tempo. Così i prezzi finali aumentano sia per il costo maggiorato delle materie prime di coltivazione, a cui servono fertilizzanti da petrolio, e quello delle benzine agricole, ovviamente derivate dai petroli, sia per ripagare le operazioni spot, “mordi e fuggi”, che operano nel mercato food, soprattutto nelle materie prime e comprimono i redditi dei produttori e delle reti di intermediari.
Se mi si permette una battuta,
il tardo capitalismo ha realizzato la meccanizzazione delle campagne e l’abolizione della piccola proprietà molto meglio di quanto avessero programmato Lenin e Stalin, con le loro campagne di collettivizzazione in Ucraina e nel Donbass.
Oggi la finanza futura occupa in media, in un mercato del tutto grigio e inverificabile agli estranei, circa dodici volte sull’intero prodotto finanziario, a prezzi costanti, dell’agricoltura mondiale. Una massa pari, in media, a quella speculativa che si muove sui petroli.
****************************************************************************************
Il tema affrontato da Giancarlo Elia Valori – l’approvigionamento delle risorse alimentari e le implicazioni globali – è, senza forse, “IL TEMA” fondamentale, prioritario e immanente nelle sorti dell’umanità.
Ma mettiamo subito, come si dice brutalmente, “i piedi nel piatto”.
Scrive Valori: «Il volume degli investimenti speculativi nel settore dopo la deregulation post-reganiana del 2000 con l’invenzione di prodotti finanziari dedicati, in particolare da parte della Goldman Sachs, seguita poi dalle altre banche d’affari globali, è passato da circa 1,5 miliardi di dollari nel 1995 a oltre 300 miliardi di dollari oggi .»….omissis
«Il “mercato nascosto” dei titoli a termine è tale da poter aggirare facilmente ogni limitazione legale delle transazioni e, come accade anche per i titoli del debito pubblico, la tecnica dell’0ver the counter, la transazione bilaterale diretta tra operatori, lascerebbe campo libero alla speculazione sui titoli a termine alimentari.»….omissis «La grande invenzione di Goldman Sachs alla quale facevamo sopra riferimento, peraltro, il Gsci (Goldman Sachs Commodity Index), a cui sottostanno materie prime che vanno dai metalli preziosi all’energia, agli alimentari, è pensato per far passare i contratti derivati sulle commodity alimentari, inevitabilmente “a breve” per la loro intrinseca, in posizioni finanziarie “a lungo”,molto più simili a un investimento finanziario standard che a un’operazione a termine su stock reali di cibo. E’ un meccanismo che induce gli investitori a rimanere sempre in fase di acquisto, indipendentemente dai prezzi e dai rendimenti previsti. Alla scadenza ogni contratto viene “reimpacchettato” in un nuovo contratto, o prodotto finanziario, che viene offerto alla clientela a condizioni spesso più vantaggiose delle precedenti. Così, i prezzi finali aumentano, e gran parte della popolazione mondiale non ha la possibilità di acquistare il cibo che ha incorporato il costo della speculazione.
Sul piano strettamente produttivo, la produzione di cibo speculation- oriented ha tutto l’interesse a favorire le grandi monocolture, che inficiano la biodiversità e rappresentano l’attività agricola e di allevamento più ecologicamente invasiva e dannosa, crea l’illusione della scarsità, spesso anche con campagne mirate sui mass media, e favorisce il passsaggio dei terreni al biofuel.»
…..omissis «In sostanza, la verticalizzazione globale del mercato del cibo permette la sinergia orizzontale tra speculazione e produzione. L’esclusione dei piccoli e medi produttori dal mercato ha reso quest’ultimo volontariamente opaco alla formazione dei prezzi reali e invece prono a sostituire i costi effettivi con le remunerazioni dei fattori di produzione ( spesso conferite ai farmers dalle stesse multinazionali) generate dai calcoli delle grandi imprese e dei cicli speculativi che insieme generano e dalle quali si fanno sostenere.»…..omissis «Occorre controllare la cessione, da parte delle multinazionali che li distribuiscono ai farmers, degli Ogm, che non aumentano la produttività media dei suoli ma sono adatti alle grandi produzioni estensive.»……omissis «Come si vede, è un mercato facilmente definibile come un oligopolio o, meglio, un cartello di produttori che si sono via via specializzati in un determinato segmento, esercitandovi un sostanziale monopolio di fatto. La DuPont, con la sua consociata Pioneer, e la Monsanto controllano il 58 per cento del mercato statunitense, il principale al mondo, delle sementi di grano, sia Ogm, sia naturali. Monsanto, dal canto suo, controlla il 70 per cento del mercato del grano transgenico, oltre il 90 per cento del sistema Ogm per la soia, e ancora il 90 per cento delle sementi Ogm per il cotone. » ……..omissis « Attualmente solo sei aziende – Basf, Bayer, Dow Chemicals, Du Pont, Monsanto e Syngenta – controllano con un cartello di fatto, l’80 per cento del mercato mondiale dei pesticidi, che era coperto da dodici corporation già nel 1994, mentre Du Pont e Monsanto controllano il 65 per cento di tutto il mercato mondiale del mais, il 44 per cento di quello della soia e coprono ben il 91 per cento del mercato delle sementi geneticamente modificate. Inoltre, cosa poco nota, le due stesse imprese globali hanno comprato il 65 per cento del mais non Ogm prodotto in Brasile, nello spazio di soli due anni.» …….omissis
Continua Valori :
« Ribadiamo: il capitalismo globale ha applicato nell’ambito di un oligopolio mondiale le stesse regole che caratterizzarono la collettivazione leninista delle campagne nei primi anni della rivoluzione bolscevica.»
-
Ora prendendo spunto dalle preoccupanti, documentate e argomentate osservazioni di Giancarlo Elia Valori, andiamo vedere se vi sono dei:
tentativi di reazione di piccoli Davide contro lo strapotere di questi giganteschi Golia di agglomerati globali.
A questo proposito è d’obbligo citare la recente sentenza del 13 maggio 2013 – Bowman v Monsanto Co.– della Corte Suprema degli Stati Uniti, in cui la Corte ha riaffermato all’unanimità quanto già sentenziato dalla Court of Appeals for the Federal Circuit ( Corte d’Appello federale ) e ha dichiarato che
l’esaurimento del brevetto non consente all’ agricoltore di riprodurre semi brevettati attraverso la semina e la raccolta senza il permesso del proprietario del brevetto.
La decisione è stata a favore del proprietario ricorrente e del brevetto, la Monsanto. Il caso ha destato molta attenzione per il suo potenziale impatto sulle tecnologie genetiche e di auto-replicanti e le preoccupazioni politiche per il passaggio di un disegno di legge redatto in parte da Monsanto e dall’attuale Giudice Supremo Clarence Thomas, che precedentemente aveva già lavorato come avvocato per la Monsanto. Anche se la stessa relatrice la giudice Elena Kagan ha cercato di circoscrivere l’ambito della sentenza restringendone l’impatto al caso specifico, ed in particolare evitando di impostare un ampio precedente giuridico.
In effetti, però, la Corte Suprema degli Stati Uniti ha rafforzato capacità di Monsanto Co. (MON) di controllare l’uso delle sue sementi geneticamente modificate, stabilendo che le aziende possono bloccare gli sforzi per aggirare i brevetti sulle tecnologie autoreplicanti.
I giudici accolta all’unanimità la richiesta di Monsanto di un risarcimento di 84.456 $ che aveva vinto in una causa contro Vernon Hugh Bowman, un agricoltore dell’Indiana. Questi invece di acquistare semi di soia resistente agli erbicidi da un concessionario Monsanto autorizzato, aveva utilizzato semi di soia da raccolti contenenti la tecnologia per piantare le sue colture.
La Court of Appeals for the Federal Circuit ha rilevato che i diritti di brevetto della Monsanto sui semi non sono “esauriti” una volta venduti al commerciante. La Corte d’Appello inoltre ha argomentato che anche se la tecnologia brevettata della Monsanto può replicare se stessa, l’acquirente non può utilizzare il prodotto di replica perché eliminerebbe diritti di brevetto della Monsanto. La corte ha concluso che Bowman ha mantenuto il diritto di vendere i semi di seconda generazione come mangime o per qualsiasi altro numero di usi, ma è stato vietato il loro reimpianto in qualsiasi forma. Il giudice ha ritenuto che la Monsanto aveva diritto al risarcimento del danno per violazione di brevetto.
-
CONSIDERAZIONI SULLE CONSEGUENZE GIURIDICHE, ECONOMICHE E SOCIALI DELLA SENTENZA
Un passo indietro.
Il 21 febbraio 2013, la Corte Suprema ascoltò le argomentazioni giuridiche della causa Bowman v Monsanto in quello che sarebbe diventato sicuramente un caso esemplare negli Stati Uniti perciò che riguarda i brevetti e la proprietà intellettuale .
Il caso riguarda il seme del gigante agrochimico Monsanto contro un piccolo agricoltore del Midwest degli Stati Uniti Vernon Bowman. Monsanto aveva citato in giudizio il signor Bowman che aveva riutilizzato i semi di soia geneticamente varietà Roundup Ready, che aveva acquistato da Monsanto l’anno prima. Monsanto sosteneva che non era giusto per loro che vendendo un prodotto brevettato, un acquirente potesse quindi utilizzarlo più e più volte.
L’agricoltore insistette affermando che stava solo facendo né più né meno quello che avevano fatto e fanno gli agricoltori come lui da secoli (riusare i semi) per sviluppare varietà di colture diverse in grado di adattarsi a diversi tipi di terreno, sfide climatiche, e malattie delle piante.
Tuttavia, questo caso non riguarda solo gli agricoltori di una nazione industriale come gli Stati Uniti, ma involve il futuro del sistema alimentare globale e avrà ripercussioni globali. Come tale, è fondamentale studiare questo caso in un contesto globale in cui un paio di multinazionali dominano la produzione alimentare mondiale.
Nel 2007, durante il picco della crisi alimentare globale, Monsanto e Cargill controllavano il mercato dei cereali, in cui entrambe le imprese aumentarono i loro profitti del 45% e del 60% rispettivamente. Nel 2009, solo cinque multinazionali , tra cui Monsanto, possedevano più della metà dei semi geneticamente venduti nel mondo.
Inoltre, Monsanto utilizza la protezione del diritto dei brevetti negli Stati Uniti e in tutto il mondo (attraverso il meccanismo WTO) contro i contadini e le agenzie agricole per garantire che i loro “prodotti biotech” possano trovare protezioni legali in grado di monopolizzare e controllare il mercato mondiale dei semi e della produzione agricola.
Ad esempio, in un comunicato stampa del febbraio 2013, la Monsanto annunciò che la società avrebbe presentato ricorso immediato contro“una recente sentenza di un giudice unico della Corte Superiore di Giustizia brasiliana … [per] garantire che la sua attività non si interrompa nel Paese “. La preoccupazione della Monsanto è che, se il caso di Mr. Bowman avesse avuto presa nella Corte Suprema , si sarebbe creato un precedente nel violare le leggi di protezione del brevetto, e, in forza di esso, gli agricoltori – non solo negli Stati Uniti ma anche in tutto il mondo – avrebbero emulato il signor Bowman, salvando i semi da ripiantare da un anno all’altro.
Inoltre, i Sostenitori della Monsanto (cioè la Business Software Alliances che rappresenta aziende come Apple e Microsoft, il grande gruppo agricolo della American Soybean Association, e una coalizione di importanti università tra cui la University of California, la Duke University, l’Emory University, l’ University of Illinois tra le altre ) sostenevano che in caso di perdita per il colosso multinazionale si creeranno battute d’arresto negli investimenti in molti campi di ricerca, quali le biotecnologie, vaccini vivi, linee cellulari, il DNA, e software per computer.
Tuttavia, l’importanza di questo caso, non sta nella interpretazione restrittiva delle leggi sui brevetti, ma nel contesto degli aspetti basilari e fondamentali della sopravvivenza umana come la stabilità delle risorse alimentari.
La sicurezza alimentare e l’accessibilità richiedono un accesso equo alla terra, all’acqua e semi, che sono tutti prodotti della natura e appartengono al patrimonio umano pubblico, e non devono poggiare sulle mani di prodotti agrochimici multinazionali.
Data la statura di Monsanto come una delle più grandi aziende alimentari e di produzione agricola del mondo, la decisione in questo caso avrà ripercussioni socio-economiche e ambientali di lunga durata a livello globale.
In termini di socioeconomia, i brevetti sulle piante continueranno ad offrire lucrosi guadagni finanziari per le imprese, e di conseguenza ostacolarenno la capacità dei piccoli agricoltori di competere sul mercato, o anche per la produzione di cibo a livello locale.
Dal punto di vista ambientale, più sentenze a favore del diritto sui brevetti dei semi geneticamente modificati avranno un impatto sempre maggiore sulla perdita di biodiversità e l’aumento dell’uso di sostanze chimiche in agricoltura e la pratica della monocoltura nella produzione alimentare mondiale.
La vittoria per Monsanto in questo caso significa che le multinazionali avranno più controllo e monopolio del patrimonio pubblico umano che è appartenuto, in divenire, per secoli, a tutto il mondo. A tal fine, il caso Bowman v Monsanto è una morale, prima che una battaglia legale su un’interpretazione restrittiva delle leggi sui brevetti degli Stati Uniti.
La morale di questo caso risiede nelle attuali e future gravi conseguenze che la decisione del caso ha su molti aspetti della vita umana, in particolare, sulle questioni relative alla fame, la povertà e la crisi strutturale del sistema alimentare globale. Oggi, in forza di tale monopolio dei semi che in tutto il mondo la Monsanto e altre aziende agrochimiche cercano di ingigantire, farà sì che medi e piccoli agricoltori e intere comunità continueranno a perdere sempre di più i loro mezzi di sussistenza.
A ciò aggiungiamo le preoccupazioni di molti che credono che le aziende non dovrebbero avere il potere di brevettabilità accompagnato da una protezione giuridica sfrenata; perché, a questa stregua dà loro un enorme potere di controllare le parti essenziali del patrimonio ereditario appartenente da millenni all’umanità, come i semi. Se la Suprema Corte si è schierata con la Monsanto, sarà poi difficile sostenere giudizialmente che altri beni e servizi pubblici – come le varietà di semi – debbano rimanere nel pubblico dominio, potrebbe diventare una pretesa illegittima.
E VEDIAMO INTANTO COSA SUCCEDE IN ITALIA E IN EUROPA
REPORT dell’ 11 novembre 2013
L’INSOSTENIBILE BREVETTO
Di Piero Riccardi e Milena Gabanelli
MILENA GABANELLI IN STUDIO
Kissinger che la sa lunga su come funziona il potere pare che un giorno abbia detto “Chi controlla il petrolio controlla le nazioni, chi controlla il cibo controlla i popoli”.
Ora, per controllare il cibo bisogna controllare il primo anello della catena che sono i semi.
I semi sono sempre stati di chi coltiva la terra e, se non gli bastano i suoi, se li va a comprare da uno che vende le sementi e la storia finisce lì. Oggi non è più così, chi acquista semi o piante la proprietà non è più la sua: Tutto nasce da un accordo firmato a Marrachesh nel 1994, sollecitato dagli Stati Uniti, che invitava tutti gli stati membri dell’Organizzazione mondiale del Commercio a trovare il modo di mettere un copyright sugli organismi viventi.
I semi sono sempre stati di chi coltiva la terra e, se non gli bastano i suoi, se li va a comprare da uno che vende le sementi e la storia finisce lì. Oggi non è più così, chi acquista semi o piante la proprietà non è più la sua: Tutto nasce da un accordo firmato a Marrachesh nel 1994, sollecitato dagli Stati Uniti, che invitava tutti gli stati membri dell’Organizzazione mondiale del Commercio a trovare il modo di mettere un copyright sugli organismi viventi.
Chi non era d’accordo rischiava di essere escluso dall’organizzazione, tutti hanno siglato il risultato è che il risultato di quell’accordo è che oggi sono in quattro a controllare la metà di tutto quello che viene coltivato.
Nel 1973 Stanley Cohen ed Herb Boyer creano in laboratorio il primo organismo geneticamente modificato. Oggi, per fare un seme, ci vuole un brevetto.Un viaggio inchiesta nell’intreccio che lega industria chimica e semi coperti da copyright.
Secondo uno studio della Fao, negli anni ‘70, c’erano 7000 compagnie sementiere e nessuna superava l’1% del mercato mondiale.
Oggi, le prime tre compagnie detengono il 53%, le prime dieci il 76% e tra queste sei coprono ben il 75% del mercato planetario dei pesticidi.

Numeri che rivelano già l’intreccio indissolubile tra chi produce semi e chi produce i veleni per le erbe indesiderate.
Dunque oggi per produrre per es. le mele devi pagare il copyright.
Nella valle dell’Adige, per coltivarle, devi firmare un contratto con una multinazionale del farmaco che ti ha venduto i semi per quella varietà di mela.
Le mele le puoi vendere solo ad un distributore autorizzato, non a chi vuoi tu.
Non solo, chi ti ha venduto i semi può venire a controllare le tue piante, per verificare se rispetti il contratto (pena, l’abbattimento a spese tue delle piante), che non hai usato altri semi.
Il tutto per avere poi nei supermercati quelle belle mele, tutte uguali, tutte belle.
L’inchiesta di Piero Riccardi ha trattato del monopolio da parte delle multinazionali dell’agroalimentare (Monsanto, Syngenta), che stanno trasformando il contadino in mezzadro, costretto a produrre quello che la grossa azienda ha deciso di produrre.
Ovvero il suo grano OGM che resiste ai suoi pesticidi, le sue mele, il suo riso ( il clearfield ) della BASF: quale è il risultato di questa situazione?
Ci avevano detto che con gli OGM si sarebbero usati meno pesticidi, che si sarebbe riusciti a produrre cibo per più persone …
Non diminuisce l’uso dei pesticidi nei campi, perché a furia di usare pesticidi le specie infestanti si rinforzano (e alla fine quei pesticidi finiscono nell’acqua e nel cibo che assimiliamo). Non porta ad una maggiore produzione: la produzione di grano e cereali non aumenta perché i terreni vengono sottratti alla produzione alimentare per il business delle biomasse.
MARIA FONTE – Economista Università Federico II Napoli
Introdurre i diritti proprietari sulle sementi e quindi creare dei blocchi proprietari, che cosa fa? Limita l’utilizzazione della semente, restringe le varietà che si possono produrre e in qualche modo limita l’innovazione. E’ assurdo che all’interno di un’organizzazione mondiale che vuole promuovere il libero commercio, poi si negozia e si firma un accordo per la protezione dei mercati.
PIERO RICCARDI– fuori campo
Brevetti come privilegi monopolistici. Brevetti che cominciano ad andare stretti alle multinazionali delle sementi e dei pesticidi. La soluzione. I semi zombi.
PAT MOONEY – ETC GROUP
I semi zombi sono semi morti, ma che possono essere riportati in vita di nuovo, attraverso un attivante chimico e solo allora sono in grado di essere riseminati ancora. E questo è perfetto per le multinazionali chimico sementiere perché così è l’agricoltore che deve andare da loro e non viceversa; non devono fare più nulla, nè ricerche, né innovazione, l’agricoltore è incastrato. Non devono neppure immagazzinare qualcosa o spedire nulla, eccetto la chiave chimica per riattivare i semi. Questa la direzione: la soluzione perfetta.
MILENA GABANELLI – in studio
Però non è vietato continuare a fare l’agricoltura tradizionale, certo che è un terreno che si restringe sempre di più. Le infestanti si adeguano, diventano resistenti e servono più pesticidi, che poi finiscono nell’acqua.
E se esiste il rischio di contaminazione genetica, vuol dire che spariranno le varietà locali di alto pregio. Ma no ci avevano sempre detto o che tutto questo serviva a tutelare l’ambiente? Ci sono rischi per la salute? Speriamo di no, però le ricadute sappiamo che si vedono nel tempo e ci sono allergie in aumento di cui nessuno sa spiegare l’origine.
I sostenitori di questa nuova tecnologia però dicono, e questo è importante, che servirà a sfamare una popolazione in crescita. Oggi quello che sappiamo è che laddove c’è carenza di cibo il problema non è di natura agro alimentare, ma è per via dei conflitti, e perché le grandi estensioni vengono sottratte alla produzione alimentare per destinarle all’uso delle biomasse. Quindi il tema è complesso e ben venga l’innovazione, ma se la ricerca pubblica abdica completamente a favore del privato, che si è inventato una macchina che non si riesce più a fermare, che modernità è ? E è moderno un pianeta dove sono in 4 controllare l’intera catena alimentare?
Come uscirne allora?

Almeno in Italia si può continuare a coltivare senza OGM [e le mele si possono prendere anche dai GAS ( Gruppi di Acquisto Solidali )senza passare dalla grande distribuzione].
Il genetista Ceccarelli propone il modello della semina per miscugli, ovvero seminare nello stesso campo più qualità di semi, per rendere più difficile la radicazione nel terreno delle piante infestanti.
09/02/2014
L’INVASIONE DELLE PANNOCCHIE MUTANTI – OLTRE METÀ DEGLI STATI È CONTRARIA, MA L’UNIONE EUROPEA IMPORRÀ IL COMMERCIO DEL MAIS OGM (LA LOBBY VINCE SEMPRE SULLA POLITICA)
Numerosi stati (tra cui l’Italia) e il Parlamento Europeo si sono espressi contro, ma una sentenza della Corte di Giustizia permette all’americana Pioneer di commerciare il suo mais transgenico, resistente a pesticidi potenzialmente dannosi per l’uomo – Dovrà decidere la Commissione, ma conteranno le astensioni (sospette) di molti Stati…
Martedì 11 febbraio sul mais transgenico l’Europa si è spaccata.
L’Europa fa tilt con gli Ogm. Sebbene diciannove Paesi abbiano votato «no», il consiglio dei ministri Affari generali dell’Ue non è riuscito a esprimere la maggioranza qualificata necessaria per non autorizzare la coltivazione del supermais 1507 dell’americana Pioneer. Il destino della pannocchia transgenica passa ora nelle mani della Commissione esecutiva che, sulla base delle disposizioni dei Trattati, ha facoltà di decidere tenendo in conto il parere tecnico positivo (espresso sei volte) dall’Agenzia per la sicurezza alimentare. I più attendono una fumata bianca. A meno che, con un colpo di scena, l’esecutivo decida di ritirare il dossier d’arbitrio per chiedere nuove evidenze scientifiche.
Chiamiamolo il pasticciaccio brutto di Rue de la Loi, storia di disfunzioni giuridiche, incertezze nazionali e regole obsolete. Può essere difficile spiegare ai cittadini che il mais geneticamente modificato a stelle e strisce potrà essere prodotto nonostante sia stato bocciato dall’Europarlamento in gennaio (parere non richiesto, ma tant’è) e da ministri degli affari europei in numero tale da rappresentare più della metà degli elettori continentali.
Altrettanto complesso  riconoscere che il numero 1507 è il secondo granturco transgenico autorizzato, col Monsanto 810 in giro da 15 anni.
riconoscere che il numero 1507 è il secondo granturco transgenico autorizzato, col Monsanto 810 in giro da 15 anni.
L’Ue ha aperto le porte, si dirà. E’ una questione che spacca l’opinione pubblica.
Il mais 1507 contiene due geni estranei alla pianta convenzionale che producono un insetticida (la tossina Bt) e garantiscono la tolleranza a un erbicida totale, il Glufosinato ammonio. I critici dicono che uccide anche falene e farfalle non pericolose e mette in pericolo l’ambiente.
Il caso è talmente divisivo da non aver mai visto i governi trovare un accordo. In presenza di una proposta di decisione scritta dalla Commissione, sentito all’avviso dell’Efsa, occorre una maggioranza qualificata per tornare indietro, sennò è l’esecutivo a disporre del dossier. Recentemente è andata così per la superpatata Amflora Basf che però si è rivelata un insuccesso commerciale.
«Siamo contro senza se e senza ma», ha giurato il ministro Enzo Moavero al termine del Consiglio dove la battaglia è stata condotta dai francesi. A favore cinque Paesi (Spagna, Regno Unito, Estonia e Svezia), mentre quattro si sono
astenuti (Germania, Portogallo, Rep. Ceca, Belgio), con una strategia che ha sollevato sospetti perché, nel non decidere, il quartetto ha consentito che la pratica andasse avanti. Interessi industriali o lobbismo? Il maltese Tonio Borg, commissario Ue per la Salute, ritiene suo dovere esprimersi positivamente in linea con le indicazioni dell’ Efsa (L’Autorità europea per la sicurezza alimentare) .
Il servizio giuridico del Consiglio ha un avviso diverso: ritiene che, sino al momento in cui non cominciano le operazioni formali di voto (ieri non ci sono state), la Commissione ha sempre la facoltà di emendare o ritirare la proposta. Il comunicato finale afferma però che «tocca ora alla Commissione autorizzare il 1507».
Un passaggio al quale 12 Paesi, tra i quali l’Italia, hanno cercato di opporsi scrivendo a Bruxelles. Ma inutilmente.
La Commissione europea ha risposto, Giovedì 13 febbraio, che non vi sono più margini, argomentando che non sono stati portati elementi nuovi e che in ogni caso le semine «potranno avvenire solo in Spagna» per ragioni climatiche. Questo perché in ogni caso agli Stati membri è lasciata libertà di scelta sulla coltivazione di questo tipo di piante. La pannocchia transgenica, insomma, si avvicina alle tavole degli europei.
La partita non è finita del tutto, e può riaprirsi il 3 marzo prossimo, quando il Consiglio discuterà ancora il tema.
In conclusione: dato che ci sono le elezioni europee tra qualche mese, la Commissione trascinerà la effettiva autorizzazione del mais TC 1507, per tramite delle procedure legali da mettere in atto, per non ufficializzarla prima del risultato delle elezioni,
ma un “uccellino” dice che sicuramente la renderà nota prima della fine del suo mandato, vale a dire in estate, dunque se ne riparla di seminare nel 2015…. Ma intanto si può seminare il MON 810 (mais geneticamente modificato ) … se non s’inventano leggi illegali.









